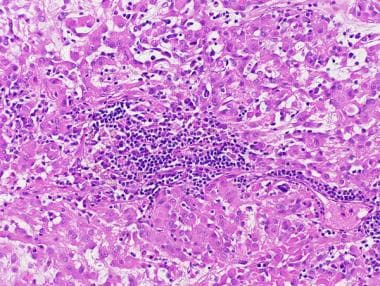

脊索样胶质瘤是一种少见的三脑室内肿瘤,因其与脊索瘤相似而得名,具有胶质纤维酸性蛋白(GFAP)——在粘液背景下呈条索状和簇状排列的阳性上皮样细胞。虽然这个肿瘤在1998年被Brat等人正式命名为一个新的实体, 1995年,万斯奇兹等人一次将舞蹈病样神经胶质瘤描述为GFAP表达的脑膜瘤。文献中报道了大约50个病例。
肿瘤通常以生长缓慢、无创性肿块的形式出现在心室前部,在组织病理学上总体表现为低度恶性,缺乏有丝分裂、血管增生或坏死。然而,脊索样胶质瘤被归类为二级肿瘤,因为它位于脑室内,附着在三脑室附近的下丘脑和鞍上结构上,通常导致不完全切除。
病理生理学
脊索样胶质瘤的起源仍不清楚。超微结构研究揭示了异常的纤毛和顶端微绒毛,提示可能是室管膜起源。通过常规比较基因组杂交对4个分支型胶质瘤进行的遗传分析没有检测到染色体不平衡。这些肿瘤的分子特征显示在TP53、CDKN2A、EGFR、CDK4或MDM2中没有异常,全部这些在星形细胞瘤的发病机制中是重要的,表明舞蹈病胶质瘤的发病机制涉及不相关的途径。
霍尔宾斯基等人用荧光原位杂交方法对5个脊索样胶质瘤进行的研究显示没有EGFR扩增。 对9p21和11q13使用特异性探针的FISH研究发现,在全部5个研究的肿瘤中,这两个位点都有一致的缺失。不TP53在这些病例中发现了突变。
流行病学
脊索样胶质瘤通常在成人中发现,平均年龄为46岁,大多数肿瘤发生在35-60岁的患者中。 女性比例为2:1。只有2例在儿童中报告,其中1例发生在近心室部位,是报告的不存在于前三脑室的病例。
临床特征
临床症状通常在几个月或几年后出现,反映了阻塞性疾病的发展脑积水或三脑室周围正常结构的侵入/压迫。 报告的症状包括头痛、恶心、视觉障碍、共济失调、内分泌功能障碍、记忆丧失和精神异常。
没有专门针对舞蹈病神经胶质瘤诊断的实验室测试。然而,在垂体功能减退舞蹈病神经胶质瘤应被视为鉴别诊断的一部分。
影像研究
脊索样胶质瘤的较大尺寸通常在1.6至4厘米之间,平均直径为2.8厘米。在影像学上,这些肿瘤通常是实心的,圆形到卵圆形,边界清楚的肿块,涉及前三脑室和下丘脑。 这些肿瘤大多显示出与下丘脑的物理连续性,有些似乎具有固有的下丘脑成分,提示这种肿瘤的潜在来源。
脑部磁共振成像通常显示肿瘤在T1加权图像上为等信号,在T2加权图像上为轻度高信号。在钆的作用下,舞蹈病神经胶质瘤强烈而均匀地增强了对比度。肿块效应并不少见,通常呈对称分布,在邻近受压结构(如视神经束、基底神经节和内囊)中引起血管源性水肿,并伴有T2加权高信号。
钆警告
钆对比剂(钆喷酸葡胺[Magnvist],钆喷酸葡胺[MultiHanse],钆喷酸胺[Omniscan],钆喷酸胺[OptiMARK],钆喷酸醇[ProHanse])与肾源性系统性纤维化(NSF)或肾源性纤维化皮肤病(NFD)的发展有关。有关更多信息,请参见电子词典主题肾源性系统性纤维化。这种疾病发生在中晚期肾病患者中,他们在接受钆基造影剂以增强磁共振成像或磁共振血管成像扫描后。
国家自然科学基金/NFD是一种使人虚弱,有时是致命的疾病。特征包括皮肤上的红色或深色斑块;皮肤灼烧、瘙痒、肿胀、硬化和紧绷;眼白上的黄色斑点;活动或伸直手臂、手、腿或脚有困难的关节僵硬;髋骨或肋骨深处的疼痛;和肌肉无力。
病理
简要讨论了脊索样胶质瘤的组织学和免疫组化结果。
组织学发现
脊索样胶质瘤在粘液性、常空泡化的高碘酸希夫[PAS]阳性背景下显示出索状和簇状上皮样肿瘤细胞。在弦突排列不太突出的区域,肿瘤细胞可以形成固体片,细胞外粘蛋白减少。细胞本身一般呈椭圆形,有大量嗜酸性胞浆,大小适中,外观相对均匀。该肿瘤具有低度的组织学外观,没有核多形性或有丝分裂活性。间质淋巴浆细胞浸润和罗素小体通常与这些肿瘤有关,这为脊索样胶质瘤的分类以及将它们与下丘脑中出现的其他胶质瘤区分开来提供了有用的线索。见下图。
带有大量炎症细胞的脊索样胶质瘤。

脊索瘤胶质瘤的特征是嵌入粘液背景的上皮样细胞索,让人想起脊索瘤。其脑内位置排除了后一种可能性。
免疫组织化学
免疫组织化学染色也有助于识别这些肿瘤,因为脊索样胶质瘤通常对GFAP、波形蛋白和CD34表现出强烈的弥漫性反应。此外,肿瘤总是表现出表皮生长因子受体(EGFR)和神经鞘氨醇/梅林的免疫反应性,没有p53、p21 (Waf-1)或MDM2蛋白的核积聚。 S100免疫反应是可变的,上皮膜抗原(EMA)可呈局灶性阳性,但通常在基质浆细胞中更明显。
增殖测量显示增殖指数与其他低级别胶质瘤一致,MIB-1率始终低于2%。神经元标记物,如突触素和色粒蛋白,具有阴性的特征, 尽管已经发表了局灶性突触素反应的例子。
分子研究没有发现一致的异常,尽管测试病例的数量很少。
预后
脊索样胶质瘤的位置以及与下丘脑和鞍上结构的密切联系必然影响手术入路和最终预后。选择大体全切除,肉眼完全切除后没有复发报道;不幸的是,这种手术被认为对大部分患者来说风险太大。
在一篇关于51例脊索样胶质瘤的文献综述中,只有23名患者接受了全切除。其余大部分(22名患者)接受了次全切除术。对38名患者进行了术后随访,显示术后即刻死亡率为32%;接受全切除的患者死亡率(8/22)高于接受次全切除的患者(4/23)。 非致命并发症包括下丘脑疾病,如短暂性尿崩症低血压、体温过低以及精神异常。
- 文章标题:三脑室脊索样胶质瘤是癌症吗?
- 更新时间:2021-05-13 09:57:32
400-029-0925




